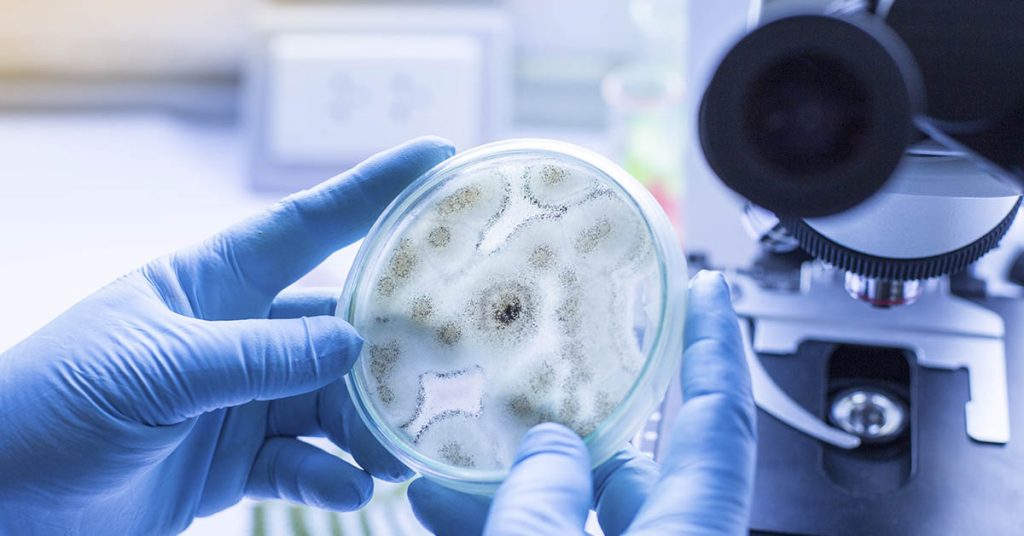
Deadly ‘Pharaoh’s Curse’ Fungus May Hold Key to Fighting Cancer - Featured image

Tattoos have become a popular form of self-expression, being more mainstream than ever before. Many people now adorn their bodies with ink, engraving unique and various designs. Negative stereotypes associated with tattoos have mostly dissipated. A significant portion of the adult population now has at least 1 tattoo. For instance, a 2024 survey showed 31%...
1545 Search Results for "cancer"
Scientists have solved a medical mystery that puzzled doctors for decades. Colon cancer cases among young adults have doubled since the mid-1990s, with one in five diagnoses now appearing in people under 55. New research shows the bacterial culprit behind this explosion and gives us the first simple screening tool to fight back. Half of...
The idea of repurposing existing drugs for cancer is an intriguing one, with people sharing stories of how drugs not originally developed for cancer ended up saving their lives. These examples have sparked curiosity and hope among patients seeking alternative therapies. While these stories are incredible, it is important to distinguish between myths and realities...
Cancer can start in almost any tissue or organ in the body and is characterized by the uncontrollable growth of abnormal cells. It is the second leading cause of death around the world, accounting for around one in every six deaths annually. The most common types of cancer in men are colorectal, prostate, lung, and...
Aspergillus flavus, also known as the Pharaoh’s Curse fungus, is rather infamous in archaeological circles. Following the excavation of various tombs, such as the one belonging to King Tutankhamun, the archaeologists who opened them experienced a series of deaths. While many considered their deaths to be the result of a curse, doctors theorized that it...
Cases of colon cancer have been on the rise for people under 50 years of age by 3% every year since 2011. According to the American Cancer Society, around 107,320 American adults will be diagnosed with colorectal cancer. This number represents an almost equal split among the sexes, with 54,510 men and 52,810 women anticipated...
Glioblastoma starts as a cancerous growth of cells in the spinal cord or brain and can happen at any age. It tends to occur more often in older adults, though, and the symptoms include headaches, nausea, seizures, blurred vision, and trouble speaking. It is the most common and aggressive type of malignant brain tumor among...
“You’re young. You’re healthy. We’re not worried about cancer.” Those words echoed in doctor’s offices 2,500 miles apart. Sarah Beran heard them in Los Angeles when she mentioned blood in her stool. Brooks Bell received the same response in North Carolina. Both women felt relieved, trusted their doctors completely, and were catastrophically wrong. Within months,...
Are you aware of the full extent of what your eyes can tell you about your health? It goes beyond actual diseases and conditions of the eyes. In fact, your optometrist can actually detect a few very serious conditions by examining your eyes. This includes diabetes and even some cancers. Understanding the manifestations of these...
Danni Duncan thought she was doing everything right. The 39-year-old Melbourne fitness coach ate 90 percent whole foods, worked out daily, and barely touched alcohol. Her four kids know her as the mom who makes homemade snacks and prioritizes health above everything else. So when doctors found a 0.7 x 0.8-inch cancer tumor in her bowel that had already...
Until very recently, the idea of a lung cancer vaccine would have been dismissed as medical science fiction. However, since August 2024, when the very first lung cancer mRNA vaccine entered human trials, this idea has rapidly become a scientific fact. Additionally, other recent innovations, such as the personalized neoantigen vaccine PGV001, have shown encouraging...
Oral cancer, also known as mouth cancer, affects the tissues within the mouth and throat. This disease can develop on the lips, gums, tongue, inner lining of the cheeks, roof, and floor of the mouth. They usually appear as white patches, red patches or tongue sores. Mouth cancer symptoms may be mistaken with canker sores....